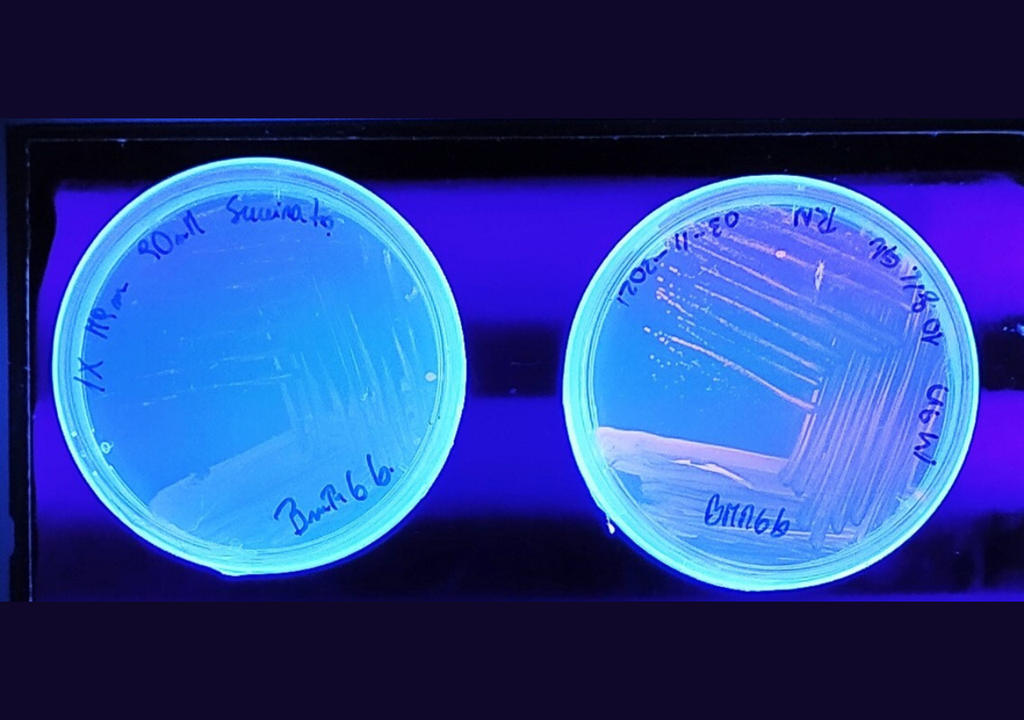
Identificación de polihidroxialcanoatos bacterianos, para lo que se sometió a la bacteria a un desbalance nutricional (derecha) vs la bacteria en condiciones nutricionales balanceadas (izquierda). Foto: Núcleo BioGem.

Demuestran potencial de bacteria patagónica para producir bioplásticos antibacterianos y antioxidantes
El estudio, desarrollado por un equipo de investigación del Núcleo Milenio BioGEM, se centró en la bacteria Janthinobacterium sp. BmR6b, nativa de la Patagonia. Demostraron que es una fuente prometedora para obtener productos con potenciales aplicaciones biomédicas.

El polihidroxibutirato (PHB) es un polímero que, al ser producido por microorganismos, resulta ser de origen renovable, biodegradable y biocompatible. En otras palabras, es un plástico sostenible y no tóxico para el organismo humano, características que lo hacen perfecto para aplicaciones como el empaquetado y los dispositivos médicos.
Teniendo en cuenta ese potencial, el investigador Mario Sepúlveda, doctorado en Biotecnología de la Universidad Técnica Federico Santa María (UTFSM) –al alero del Núcleo Milenio BioGEM–, demostró que una bacteria nativa de la Patagonia, denominada Janthinobacterium sp. BmR6b, puede producir el bioplástico, pero también la violaceína, un pigmento con capacidades antibacterianas y antioxidantes.
El estudio buscaba determinar las bases moleculares de la síntesis de PHB y violaceína en la bacteria patagónica, para establecer la producción simultánea de ambos compuestos y evaluar su integración como un bioplástico antibacteriano.
Sus resultados permitieron establecer las condiciones de cultivo para esta coproducción; logrando integrar los compuestos y evitando que la bacteria Staphylococcus aureus (que puede producir desde infecciones cutáneas a neumonía) se adhiera a las microfibras creadas, comprobando además, que la presencia de la violaceína reduce el riesgo de contaminación.
“Durante la tesis se logró la coproducción de ambos compuestos en un biorreactor, y la integración del bioplástico PHB con el antibiótico violaceína se logró con una técnica llamada electrospinning (electrohilado, en español), que consiste en la generación de microfibras con la aplicación de un campo eléctrico. Esto se realizó en colaboración con la Dra. Francisca Acevedo y el Dr. Rodrigo Navia de la Universidad de La Frontera. Estas microfibras se depositan sobre una superficie, generando un entramado que recibe el nombre de scaffold (andamio), que tiene una apariencia similar a la de un tejido; contiene alta porosidad y superficie de contacto, otorgando diversas aplicaciones”, explica Mario Sepúlveda.

Una de esas aplicaciones es su uso como soporte para el crecimiento de células de tejido conectivo en animales y humanos. “Estas aplicaciones son útiles para el desarrollo de dispositivos para ingeniería de tejidos, donde se busca imitar el tejido conectivo humano para promover el crecimiento de las células que van a dar lugar a la reparación de, por ejemplo, una herida o quemadura”, agrega el investigador.
Los próximos pasos del equipo investigador
La tesis de Sepúlveda logró generar un andamio de PHB combinado con violaceína que tuviera actividad antioxidante y antibacteriana, las cuales son beneficiosas para un potencial dispositivo en ingeniería de tejidos, ya que disminuye tanto el estrés oxidativo asociado a la mejora de la reparación de una lesión, como el riesgo de contracción de infecciones asociadas a bacterias, como Staphylococcus aureus o Micrococcus luteus (que puede causar shock séptico, artritis séptica, endocarditis, meningitis y neumonía cavitaria, por ejemplo).

“El siguiente paso es validar la tecnología en modelos vivos (in vivo) para evaluar el efecto del uso de este andamio en la regeneración de lesiones cutáneas de alta complejidad”, dice el investigador.
La validación de un producto a partir de esta investigación requerirá tanto pruebas para evaluar viabilidad y proliferación de cultivos celulares asociados a tejidos humanos y animales (pruebas in vitro), como en modelos preclínicos.
No te pierdas la última hora de Meteored y disfruta de todos nuestros contenidos en Google Discover totalmente GRATIS
+ Seguir a Meteored